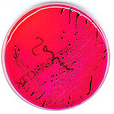

Surprising Science
All Stories
Bone marrow stem cells suspended in X-ray-visible micro bubbles can be used to dramatically improve the body’s ability to build new blood vessels in the upper leg, scientists have found.
A German team has turned tales of invisibility cloaks, made famous by Grimm’s fairy tales and Harry Potter, into a potential – albeit a small – reality. About 0.00005 inches in fact.
Nicole Lazzaro may just have the job you’ve always wanted. At the very least, she runs the focus groups you’ve always wanted to join. As founder and president of consulting […]
Fear of a water-borne disease outbreak is gripping Fiji in the aftermath of Cyclone Tomas which battered the South Pacific island nation last Friday, displacing 20,000 people.
Academics have decided that you stop being young at 35 – a recent milestone for The Telegraph’s Harry de Quetteville. Better fetch the pipe and slippers!
IMAX Hubble 3D, hitting the theaters on March 19, features the most famous space telescope of all, the Hubble, launched in April 1990. Soaring above the earth’s atmosphere, it gives […]
Robert Kirshner of Harvard is one of the world’s most distinguished astrophysicists. So to kick off his Big Think interview, we asked the hardest-hitting astrophysics question in our arsenal: what’s […]
Scientists have established common bloodsucking insect the leech as a model for a study of reproductive behavior, with some twisting and turning results.
Blood purification might sound evocative of ethnic cleansing and genocide, but the term in fact refers to a new technology designed to deactivate potential harmful bacteria in blood.
The famous Great Red Spot which can be seen on planet Jupiter is not what astronomers previously thought it was. Turns out, the red spot is a warm patch in a cold storm!
If you look at the evolution of the automobile, you’ll notice that there have never been any radical changes. Will we see any in the near future? Director of Advanced […]
Each of us is unique and special. So too are the bacterial communities infesting our grimy palms. As we move through the world, we deposit a potentially incriminating microbial film […]
Sufferers of diabetes need to be extra-careful about controlling their food intake and weight, but have the double problem of needing treatment which makes them hungry.
The way scientists conceive of time has change tremendously since Newton proposed the first concrete picture of time, and these new models open up the possibility of time travel.
Everything you think you know about substance abuse is wrong, according to a new book “Addiction: A Disorder of Choice,” which says addiction is “voluntary behavior.”
Outrage has been sparked after a London fertility clinic began raffling a human egg and IVF treatment to one lucky winner in celebration of its relationship with an American counterpart.
A Federal judge has ruled that there is no causal relationship between a mercury-containing agent used in vaccines and the occurrence of autism in those who have been vaccinated.
A new study shows that being overweight doubles the effect of alcohol on the liver, substantially increasing the likelihood of contracting diseases like cirrhosis.
The world’s biggest physics experiment will suffer another setback in two years time when it is expected to be shut down for repairs, pushing full operating capacity back another year.
President Obama has delayed his visit to Asia to push for a vote on healthcare reform here at home before the Congress takes its Easter recess at the end of the month.
This morning Big Think is pleased to present a kind of double feature: a full-length interview with CUNY theoretical physicist, futurist, and radio host Michio Kaku, and the launch of his […]
A new kind of brain scan has been developed which can effectively read a person’s mind, according to researchers who have been able to differentiate brain activity liked to memory.
Fear, guilt and shame often push people into coping behaviors, which ease the momentary pain, even as they hurt long-term. Smoking, for instance. Or binge-drinking. And one path to fear, […]
Chickens don’t follow the mammalian model in the way that gender is assigned to them before birth according to discoveries by scientists at the University of Edinburgh.
Remarkably well preserved genetic information has been found in the fossilised eggshells of an extinct species of elephant bird from Madagascar, the biggest bird ever to walk this earth.
A new study using mice has revealed that the root of psychiatric disorder attention deficit/hyperactivity disorder (ADHD) might be found in an overactive protein.
Four in 10 men over the age of 75 are still having sex—or so they say—despite only two in 10 women 75 or older claiming the same, according to a new survey.
My soon-to-be seventy year old father called me around dinnertime on Saturday. He was having a problem adding some text to his website, he said, and wanted me to take […]
What if you could bid on a parking spot eBay-style? Let’s say you have an emergency doctors appointment; you might be willing to pay $50. But if you’re just meeting […]
The New York Times’ resident ethicist, Randy Cohen, had some confused but caustic advice for a parent who wrote in with the following quandary: My 9-year-old son, who has attention-deficit […]